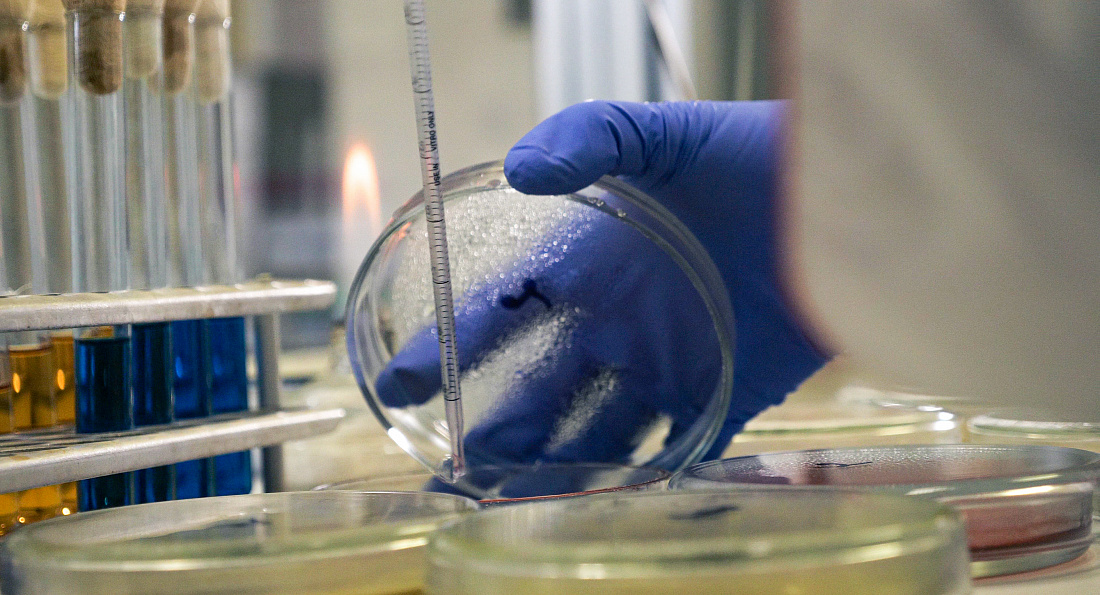

Обследование зернобобовых культур на бактериозы
С 31 мая по 8 июня при содействии Алтайского филиала ФГБУ «Центр оценки качества зерна» научный сотрудник лаборатории бактериологии и анализа ГМО испытательного лабораторного центра Всероссийского центра карантина растений Ирина Игнатьева приняла участие в обследовании полей в рамках мониторинга бактериальных болезней зернобобовых культур. Целью визита послужил сбор растительного материала растений хозяев бактериального ожога гороха Pseudomonas syringae pv. рisi для дальнейшего пополнения коллекции бактериальных культур и применения полученных растительных экстрактов в валидации методов диагностики возбудителя бактериоза по теме: «Разработка методических рекомендаций по выявлению и идентификации возбудителя бактериального ожога гороха Pseudomonas syringae pv. рisi». Главная цель исследования - внедрение методов ПЦР-диагностики при выявлении и идентификации возбудителей бактериозов из экстрактов образцов зернобобовых культур.
К числу значимых бактериальных фитопатогенов зернобобовых культур относят возбудителя ржаво-бурой пятнистости сои Сurtobacterium flaccumfaciens pv. flaccumfaciens и угловатую пятнистость фасоли Pseudomonas savastanoi pv. рhaseolicola, которые входят в список вредных организмов сои, имеющих карантинное значение для Китая. Данные бактериозы вызывают снижение урожая и качества зерна зернобобовых культур. Интродукция фитопатогенных бактерий в новые регионы может произойти с семенным материалом, зараженным бактериальной инфекцией в латентном состоянии, что вызывает серьезные проблемы при производстве зернобобовых культур.
С целью выявления данных бактериозов сотрудником лаборатории бактериологии и анализа ГМО испытательного лабораторного центра Всероссийского центра карантина растений было отобрано 28 образцов растительного и семенного материала сои и гороха на полях Алтайского края. В Косихинском районе взяты пробы растительного материала с полей семенного гороха сорта «Алтайский усатый» в ООО «Фермерское хозяйство Устинова В. И.». В этом регионе хозяйство Устинова В. И. является одним из лидеров производства элитных семян сельскохозяйственных культур, таких как гречиха, горох, пшеница, чечевица.
К числу значимых бактериальных фитопатогенов зернобобовых культур относят возбудителя ржаво-бурой пятнистости сои Сurtobacterium flaccumfaciens pv. flaccumfaciens и угловатую пятнистость фасоли Pseudomonas savastanoi pv. рhaseolicola, которые входят в список вредных организмов сои, имеющих карантинное значение для Китая. Данные бактериозы вызывают снижение урожая и качества зерна зернобобовых культур. Интродукция фитопатогенных бактерий в новые регионы может произойти с семенным материалом, зараженным бактериальной инфекцией в латентном состоянии, что вызывает серьезные проблемы при производстве зернобобовых культур.
С целью выявления данных бактериозов сотрудником лаборатории бактериологии и анализа ГМО испытательного лабораторного центра Всероссийского центра карантина растений было отобрано 28 образцов растительного и семенного материала сои и гороха на полях Алтайского края. В Косихинском районе взяты пробы растительного материала с полей семенного гороха сорта «Алтайский усатый» в ООО «Фермерское хозяйство Устинова В. И.». В этом регионе хозяйство Устинова В. И. является одним из лидеров производства элитных семян сельскохозяйственных культур, таких как гречиха, горох, пшеница, чечевица.
16.06.2021